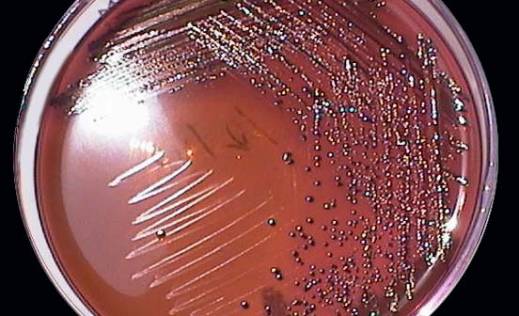
Kako ešerihija opstaje?

- Alternativna medicina
- Bolesti
- Bolesti bubrega
- Bolesti bubrega
Zdravi Bubrezi: 5 Važnih Saveta za Prevenciju Problema
Bubrezi su jedan od najvažnijih organa, neki ih nazivaju i detoksikacionim mašinama, zato bi definitivno trebalo bolje da brinemo o njima. Ključan...Kamen u bubreguKamen u žučnoj kesi- Vaša žučna kesa je mali organ u obliku kruške na desnoj strani stomaka, odmah ispod jetre. Žučna kesa...Prirodni lekoviZDRAVSTVENE PREDNOSTI biljke UVE
Biljka uva je poznata i kao medveđe grožđe. Dobila je drugi naziv po tome što se medvedima najčešće hrane njenim plodovima. Medveđe grožđe,...
- Bolesti kicme
- Bol u leđima
Bol u donjem delu leđa: Zašto nastaje, kako se leči i šta možete učiniti da ga sprečite?
Bol u donjem delu leđa jedan je od najčešćih zdravstvenih problema danas, a može pogoditi ljude svih uzrasta. Bez obzira na...Bolesti kicmeKako pomoći kod bolova u leđima?
Kako pomoći kod bolova u leđima? Hajde da vidimo šta možete uraditi za bolove u donjem delu leđa. Verovatno nema osobe koja...SimptomiZašto ne bi trebalo da tražimo informacije o svojim simptomima na internetu?
Priznajmo, ali ne, svi smo bar jednom pretraživali svoje simptome na internetu i povezivali ih s nekom bolešću. To samo po sebi...
- Bolesti kostiju
- ArtrozaArtroza kolenaBol u karliciBol u kostimaBol u zglobovimaGihtni artritisIšijasKalcifikacijaMortonov neuromOsteoartritisArtroza
Artroza kolena može biti efikasno lečena
Artroza ! Bolovi u kolenu koji se često javljaju sa godinama mogu da budu vrlo neprijatni i u mnogome utiču na...Bol u kostima4 navike za jače kosti u svim dobnim periodima VIDEO
Navike za jače kosti Nikada nije prerano niti prekasno da brinite o zdravlju svojih kostiju! Ova izreka naglašava da je briga o...Bolesti kostijuRecept za zdrave kosti, zube i mišiće
Zdrave kosti i kada se spomene dodataka ishrani, mišljenja javnosti se jako razlikuju. Neki veruju u njihovu efikasnost, dok drugi misle...
- Bolesti krvi
- AnemijaAnemija ili MalokrvnostCirkulacija krviČišćenje krvnih sudovaGusta krvHematurijaHemofilijaHemoglobinHipokalcemijaKapilariGusta krv
Gusta krv -prirodni napici za kontrolu : Kako ih napraviti kod kuće i zašto su važni za zdravlje?
Gusta krv, poznata i kao hiperkoagulabilnost, stanje je u kojem krv postaje viskoznija od normalne, što povećava rizik od stvaranja krvnih...HipokalcemijaŠta se dešava kada je nivo kalcijuma u krvi prenizak?
Hipokalcemija je stanje kada je nivo kalcijuma u krvi (u krvi, ne u kostima!) prenizak. Stanje je izlečivo. Hipokalcemija se javlja kada...HipokalcemijaHipokalcemija! Šta se dešava kada je nivo kalcijuma u krvi prenizak?
Hipokalcemija je kada je nivo kalcijuma u krvi (u krvi, ne u kostima!) prenizak. Ovo stanje je izlečivo. Hipokalcemija se javlja kada...
- Bolesti mišićno koštanog i vezivnog tkiva
- Bol
Kronična bol može značajno smanjiti kvalitet života
Hroničan bol može snažno uticati na kvalitet života pojedinca. Šta je hroničan bol, kako možemo sebi pomoći i, što je najvažnije,...SedenjeSedenje povećava rizik od smrti: Saveti stručnjaka za očuvanje zdravlja (VIDEO)
Sedenje! Iako se često istražuje i razmatra uticaj dugotrajnog sedenja na zdravlje, tačno je da postoji veza između preteranog sedenja i...SedenjeSedenje može imati ozbiljan negativan uticaj na opšte zdravlje (VIDEO)
Sedenje može da nam skrati život! Veća je verovatnoća da ćemo umreti ranije iz bilo kog razloga ako dugo sedimo. Ne pomaže...
- Bolesti nervnog sistema
- Adenoleukodistrofija (ALD)Alchajmerova bolestAneurizmaDemencijaDepresijaDistonijaEMDR terapijaEpifizaEpilepsijaFrontobazalna povredaStres
Kako pisanje pretvara stres u mir
Pisanje kao put do unutrašnjeg mira Ponekad se čini da su naše misli poput prebukiranog aerodroma – previše letova, premalo mesta na...AneurizmaAneurizma aorte:Stanje koje zahteva hitnu pomoć
Aneurizma aorte: uzrok, simptomi i lečenje Šta je aneurizma aorte? Aneurizma aorte predstavlja proširenje aorte, glavne arterije koja izlazi iz srca i snabdeva...Alchajmerova bolestAlchajmerova bolest : Noćno svetlosno zagađenje i rizik od opasne bolesti
Alchajmerova bolest, vodeći oblik demencije koji pogađa milione ljudi širom sveta, dugo je bila posmatrana kao bolest starenja. Međutim, istraživanja ukazuju...
- Bolesti pluća
- Aktinomikoza plućaAktinomioza plućaAstmaBol u grudimaBronhitisČiščenje plućaEdem plućaGripHOBPHrkanjeGrip
Dok traje sezona gripa, jedna česta greška i dalje produžava oporavak i vodi u komplikacije
Hladniji dani i više vremena provedenog u zatvorenom prostoru idealni su uslovi za širenje respiratornih infekcija. Lekari upozoravaju da je sezona...Bol u grudimaOštar Bol u Grudima: Uzroci, Simptomi i Kada Potražiti Pomoć
Oštar bol u grudima je simptom koji nikada ne treba zanemariti. Iako može imati različite uzroke, od benignih do ozbiljnih stanja,...Bol u grudimaBolovi u grudima! 5 razloga zašto mogu da se jave
Bolovi u grudima mogu da se jave na primer zbog upale pluća ili neke druge bolesti, ne nužno zbog srčanog udara. Ali...
- Bolesti sistema za varenje
- Bolesti crevaČirČišćenje debelog crevaGastritisKlistirNetolerancija na laktozuOpstipacijaRak debelog crevaNetolerancija na laktozu
Zašto dolazi do netolerancije na laktozu?
Netolerancije na laktozu-Sa starenjem se postepeno pogoršavaju fiziološke funkcije organizma, a time i održavanje ravnoteže u telu. Što se tiče varenja, javljaju...Bolesti crevaZarazne bolesti creva koje nam prete leti
Zarazne bolesti creva su najčešće zarazne bolesti na svetu. Zajedničko im je to što se prenose fekalno-oralnim putem, što znači da...Bolovi u stomakuDa li vam se i stomak muči kada ste nervozni?
Da li ste nervozni? Mući vas stomak? Nervoza i stres mogu imati značajan uticaj na rad digestivnog sistema. Kada smo nervozni,...
- Bolesti srca i krvnih sudova
- AneurizmaAritmijaAterosklerozaBradiaritmijaInfarktInsuficijencija zaliska plućne arterijeKardiopulmonalna reanimacija-CPRKardiovaskularne bolestiKateterizacija srcaKoronarna arterijska bolestBolesti srca i krvnih sudova
Revolucija u kardiologiji: Srce u stanju da stvara nove arterije bez operacije
Naučnici su nedavno otkrili gen koji omogućava srcu da samostalno formira nove arterije, što predstavlja značajan korak ka regeneraciji srca nakon...Krvni pritisakKako efikasno kontrolisati krvni pritisak i zašto on raste?
Krvni pritisak je jedan od ključnih pokazatelja zdravlja kardiovaskularnog sistema, a njegovo pravilno održavanje smanjuje rizik od ozbiljnih stanja poput srčanog...Povišen krvni pritisakKako prirodno regulisati krvni pritisak: Koraci ka zdravijem životu VIDEO
Krvni pritisak je jedan od ključnih pokazatelja našeg zdravlja, a njegovo održavanje u normalnim granicama od vitalnog je značaja za očuvanje...
- Bolesti uha, grla i nosa
- Aparati za sluhBolovi u ušimaKijanjeKrvarenje iz nosaKrvarenje iz uhaLaringitisMenierova bolestPolipi u nosuPromuklostsinusiŠtitna žlezda
Vaš Vodič Kroz Čvoriće na Štitnoj Žlezdi: Kada je Vreme za Brigu?
Čvoriće na Štitnoj Žlezdi, mala ali moćna, igra ključnu ulogu u našem organizmu, regulišući metabolizam i mnoge druge važne funkcije. Nažalost, problemi...Krvarenje iz nosaKrvarenje iz nosa: Najčešći razlozi epistakse
Krvarenje iz nosa često nas može uplašiti, ali obično nije razlog za zabrinutost. Najčešće prestane samo od sebe, ali ako uzimate...Krvarenje iz nosaRazlozi za glavobol i krvarenje iz nosa
Krvarenje iz nosa, poznato i kao epistaksa, i glavobolje su uobičajeni zdravstveni problemi koji se mogu pojaviti istovremeno ili odvojeno. Uzroci...
- Bolesti debelog creva
- Analna fisuraČir na dvanaestopalačnom crevuDivertikulozaDizenterijaHemoroidiHamamelis gelIBDKronova bolestKrv u stoliciNeravnoteža crevne floreBakterije
Bakterije u Crevima: Kako Zdrav Mikrobiom Podržava Naše Zdravlje
Zašto su bakterije u crevima važne? Naše telo je dom za bilione mikroorganizama, od kojih se mnogi nalaze u crevima. Ove bakterije...Sindrom kratkog crevaKako i zašto nastaje sindrom kratkog creva i kako se nadoknađuje njegova funkcija
Sindrom kratkog creva nastaje kao posledica uklanjanja većeg dela tankog creva, obično više od pola njegove dužine. Tanko crevo je primarno...Hemoroidi7 razloga zašto može da svrbi zadnjica
Koža, probavni problemi i hronične bolesti su svi mogući krivci da vas svrbi zadnjica ali i neprijatan problem. Svrbežna guza može biti...
- Onkologija
- Prirodni lekovi
- Lekovite biljke
- Dermatologija
- Alternativna medicina
- Bolesti
- Bolesti bubrega
- Bolesti bubrega
Zdravi Bubrezi: 5 Važnih Saveta za Prevenciju Problema
Bubrezi su jedan od najvažnijih organa, neki ih nazivaju i detoksikacionim mašinama, zato bi definitivno trebalo bolje da brinemo o njima. Ključan...Kamen u bubreguZašto se javlja kamen u žučnoj kesi? Žučna kesa sadrži probavnu tečnost, nazvanu žuč, koja se oslobađa u vaš tanko crevo
Kamen u žučnoj kesi- Vaša žučna kesa je mali organ u obliku kruške na desnoj strani stomaka, odmah ispod jetre. Žučna kesa...Prirodni lekoviZDRAVSTVENE PREDNOSTI biljke UVE
Biljka uva je poznata i kao medveđe grožđe. Dobila je drugi naziv po tome što se medvedima najčešće hrane njenim plodovima. Medveđe grožđe,...
- Bolesti kicme
- Bol u leđima
Bol u donjem delu leđa: Zašto nastaje, kako se leči i šta možete učiniti da ga sprečite?
Bol u donjem delu leđa jedan je od najčešćih zdravstvenih problema danas, a može pogoditi ljude svih uzrasta. Bez obzira na...Bolesti kicmeKako pomoći kod bolova u leđima?
Kako pomoći kod bolova u leđima? Hajde da vidimo šta možete uraditi za bolove u donjem delu leđa. Verovatno nema osobe koja...SimptomiZašto ne bi trebalo da tražimo informacije o svojim simptomima na internetu?
Priznajmo, ali ne, svi smo bar jednom pretraživali svoje simptome na internetu i povezivali ih s nekom bolešću. To samo po sebi...
- Bolesti kostiju
- ArtrozaArtroza kolenaBol u karliciBol u kostimaBol u zglobovimaGihtni artritisIšijasKalcifikacijaMortonov neuromOsteoartritisArtroza
Artroza kolena može biti efikasno lečena
Artroza ! Bolovi u kolenu koji se često javljaju sa godinama mogu da budu vrlo neprijatni i u mnogome utiču na...Bol u kostima4 navike za jače kosti u svim dobnim periodima VIDEO
Navike za jače kosti Nikada nije prerano niti prekasno da brinite o zdravlju svojih kostiju! Ova izreka naglašava da je briga o...Bolesti kostijuRecept za zdrave kosti, zube i mišiće
Zdrave kosti i kada se spomene dodataka ishrani, mišljenja javnosti se jako razlikuju. Neki veruju u njihovu efikasnost, dok drugi misle...
- Bolesti krvi
- AnemijaAnemija ili MalokrvnostCirkulacija krviČišćenje krvnih sudovaGusta krvHematurijaHemofilijaHemoglobinHipokalcemijaKapilariGusta krv
Gusta krv -prirodni napici za kontrolu : Kako ih napraviti kod kuće i zašto su važni za zdravlje?
Gusta krv, poznata i kao hiperkoagulabilnost, stanje je u kojem krv postaje viskoznija od normalne, što povećava rizik od stvaranja krvnih...HipokalcemijaŠta se dešava kada je nivo kalcijuma u krvi prenizak?
Hipokalcemija je stanje kada je nivo kalcijuma u krvi (u krvi, ne u kostima!) prenizak. Stanje je izlečivo. Hipokalcemija se javlja kada...HipokalcemijaHipokalcemija! Šta se dešava kada je nivo kalcijuma u krvi prenizak?
Hipokalcemija je kada je nivo kalcijuma u krvi (u krvi, ne u kostima!) prenizak. Ovo stanje je izlečivo. Hipokalcemija se javlja kada...
- Bolesti mišićno koštanog i vezivnog tkiva
- Bol
Kronična bol može značajno smanjiti kvalitet života
Hroničan bol može snažno uticati na kvalitet života pojedinca. Šta je hroničan bol, kako možemo sebi pomoći i, što je najvažnije,...SedenjeSedenje povećava rizik od smrti: Saveti stručnjaka za očuvanje zdravlja (VIDEO)
Sedenje! Iako se često istražuje i razmatra uticaj dugotrajnog sedenja na zdravlje, tačno je da postoji veza između preteranog sedenja i...SedenjeSedenje može imati ozbiljan negativan uticaj na opšte zdravlje (VIDEO)
Sedenje može da nam skrati život! Veća je verovatnoća da ćemo umreti ranije iz bilo kog razloga ako dugo sedimo. Ne pomaže...
- Bolesti nervnog sistema
- Adenoleukodistrofija (ALD)Alchajmerova bolestAneurizmaDemencijaDepresijaDistonijaEMDR terapijaEpifizaEpilepsijaFrontobazalna povredaStres
Kako pisanje pretvara stres u mir
Pisanje kao put do unutrašnjeg mira Ponekad se čini da su naše misli poput prebukiranog aerodroma – previše letova, premalo mesta na...AneurizmaAneurizma aorte:Stanje koje zahteva hitnu pomoć
Aneurizma aorte: uzrok, simptomi i lečenje Šta je aneurizma aorte? Aneurizma aorte predstavlja proširenje aorte, glavne arterije koja izlazi iz srca i snabdeva...Alchajmerova bolestAlchajmerova bolest : Noćno svetlosno zagađenje i rizik od opasne bolesti
Alchajmerova bolest, vodeći oblik demencije koji pogađa milione ljudi širom sveta, dugo je bila posmatrana kao bolest starenja. Međutim, istraživanja ukazuju...
- Bolesti pluća
- Aktinomikoza plućaAktinomioza plućaAstmaBol u grudimaBronhitisČiščenje plućaEdem plućaGripHOBPHrkanjeGrip
Dok traje sezona gripa, jedna česta greška i dalje produžava oporavak i vodi u komplikacije
Hladniji dani i više vremena provedenog u zatvorenom prostoru idealni su uslovi za širenje respiratornih infekcija. Lekari upozoravaju da je sezona...Bol u grudimaOštar Bol u Grudima: Uzroci, Simptomi i Kada Potražiti Pomoć
Oštar bol u grudima je simptom koji nikada ne treba zanemariti. Iako može imati različite uzroke, od benignih do ozbiljnih stanja,...Bol u grudimaBolovi u grudima! 5 razloga zašto mogu da se jave
Bolovi u grudima mogu da se jave na primer zbog upale pluća ili neke druge bolesti, ne nužno zbog srčanog udara. Ali...
- Bolesti sistema za varenje
- Bolesti crevaČirČišćenje debelog crevaGastritisKlistirNetolerancija na laktozuOpstipacijaRak debelog crevaNetolerancija na laktozu
Zašto dolazi do netolerancije na laktozu?
Netolerancije na laktozu-Sa starenjem se postepeno pogoršavaju fiziološke funkcije organizma, a time i održavanje ravnoteže u telu. Što se tiče varenja, javljaju...Bolesti crevaZarazne bolesti creva koje nam prete leti
Zarazne bolesti creva su najčešće zarazne bolesti na svetu. Zajedničko im je to što se prenose fekalno-oralnim putem, što znači da...Bolovi u stomakuDa li vam se i stomak muči kada ste nervozni?
Da li ste nervozni? Mući vas stomak? Nervoza i stres mogu imati značajan uticaj na rad digestivnog sistema. Kada smo nervozni,...
- Bolesti srca i krvnih sudova
- AneurizmaAritmijaAterosklerozaBradiaritmijaInfarktInsuficijencija zaliska plućne arterijeKardiopulmonalna reanimacija-CPRKardiovaskularne bolestiKateterizacija srcaKoronarna arterijska bolestBolesti srca i krvnih sudova
Revolucija u kardiologiji: Srce u stanju da stvara nove arterije bez operacije
Naučnici su nedavno otkrili gen koji omogućava srcu da samostalno formira nove arterije, što predstavlja značajan korak ka regeneraciji srca nakon...Krvni pritisakKako efikasno kontrolisati krvni pritisak i zašto on raste?
Krvni pritisak je jedan od ključnih pokazatelja zdravlja kardiovaskularnog sistema, a njegovo pravilno održavanje smanjuje rizik od ozbiljnih stanja poput srčanog...Povišen krvni pritisakKako prirodno regulisati krvni pritisak: Koraci ka zdravijem životu VIDEO
Krvni pritisak je jedan od ključnih pokazatelja našeg zdravlja, a njegovo održavanje u normalnim granicama od vitalnog je značaja za očuvanje...
- Bolesti uha, grla i nosa
- Aparati za sluhBolovi u ušimaKijanjeKrvarenje iz nosaKrvarenje iz uhaLaringitisMenierova bolestPolipi u nosuPromuklostsinusiŠtitna žlezda
Vaš Vodič Kroz Čvoriće na Štitnoj Žlezdi: Kada je Vreme za Brigu?
Čvoriće na Štitnoj Žlezdi, mala ali moćna, igra ključnu ulogu u našem organizmu, regulišući metabolizam i mnoge druge važne funkcije. Nažalost, problemi...Krvarenje iz nosaKrvarenje iz nosa: Najčešći razlozi epistakse
Krvarenje iz nosa često nas može uplašiti, ali obično nije razlog za zabrinutost. Najčešće prestane samo od sebe, ali ako uzimate...Krvarenje iz nosaRazlozi za glavobol i krvarenje iz nosa
Krvarenje iz nosa, poznato i kao epistaksa, i glavobolje su uobičajeni zdravstveni problemi koji se mogu pojaviti istovremeno ili odvojeno. Uzroci...
- Bolesti debelog creva
- Analna fisuraČir na dvanaestopalačnom crevuDivertikulozaDizenterijaHemoroidiHamamelis gelIBDKronova bolestKrv u stoliciNeravnoteža crevne floreBakterije
Bakterije u Crevima: Kako Zdrav Mikrobiom Podržava Naše Zdravlje
Zašto su bakterije u crevima važne? Naše telo je dom za bilione mikroorganizama, od kojih se mnogi nalaze u crevima. Ove bakterije...Sindrom kratkog crevaKako i zašto nastaje sindrom kratkog creva i kako se nadoknađuje njegova funkcija
Sindrom kratkog creva nastaje kao posledica uklanjanja većeg dela tankog creva, obično više od pola njegove dužine. Tanko crevo je primarno...Hemoroidi7 razloga zašto može da svrbi zadnjica
Koža, probavni problemi i hronične bolesti su svi mogući krivci da vas svrbi zadnjica ali i neprijatan problem. Svrbežna guza može biti...
- Onkologija
- Prirodni lekovi
- Lekovite biljke
- Dermatologija